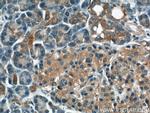
DYNLT1 Antibody in Immunohistochemistry (Paraffin) (IHC (P))

Search
Proteintech
DYNLT1 Polyclonal Antibody
{{$productOrderCtrl.translations['antibody.pdp.commerceCard.promotion.promotions']}}
{{$productOrderCtrl.translations['antibody.pdp.commerceCard.promotion.viewpromo']}}
{{$productOrderCtrl.translations['antibody.pdp.commerceCard.promotion.promocode']}}: {{promo.promoCode}} {{promo.promoTitle}} {{promo.promoDescription}}. {{$productOrderCtrl.translations['antibody.pdp.commerceCard.promotion.learnmore']}}

Please note: We are reviewing Western blot images included in the antibody testing data in our catalog, including those provided by third parties. Unless expressly labeled or annotated as “raw-unedited”, Western blot images included in the antibody testing data in our catalog may have been edited, optimized or otherwise adjusted for presentation.
产品信息
11954-1-AP
种属反应
已发表种属
宿主/亚型
分类
类型
抗原
偶联物
形式
浓度
规格
纯化类型
保存液
内含物
保存条件
运输条件
产品详细信息
Immunogen sequence: MEDYQAAEE TAFVVDEVSN IVKEAIESAI GGNAYQHSKV NQWTTNVVEQ TLSQLTKLGK PFKYIVTCVI MQKNGAGLHT ASSCFWDSST DGSCTVRWEN KTMYCIVSAF GLSI (1-113 aa encoded by BC029412)
靶标信息
Acts as one of several non-catalytic accessory components of the cytoplasmic dynein 1 complex that are thought to be involved in linking dynein to cargos and to adapter proteins that regulate dynein function. Cytoplasmic dynein 1 acts as a motor for the intracellular retrograde motility of vesicles and organelles along microtubules. Binds to transport cargos and is involved in apical cargo transport such as rhodopsin-bearing vesicles in polarized epithelia. Is involved in intracellular targeting of D-type retrovirus gag polyproteins to the cytoplasmic assembly site. May also be a accessory component of axonemal dynein. Plays a role in neuronal morphogenesis; the function is independent of cytoplasmic dynein and seems to be coupled to regulation of the actin cytoskeleton by enhancing Rac1 activity. The function in neurogenesis may be regulated by association with a G-protein beta-gamma dimer. May function as a receptor-independent activator of heterotrimeric G-protein signaling; the activation appears to be independent of a nucleotide exchange. Plays a role in regulating neurogenesis; inhibits the genesis of neurons from precursor cells during cortical development presumably by antagonizing ARHGEF2. Involved in the regulation of mitotic spindle orientation.
仅用于科研。不用于诊断过程。未经明确授权不得转售。
生物信息学
蛋白别名: Activator of G-protein signaling 2; AGS2; Dynein light chain Tctex-type 1; dynein light chain Tctex-type 1D; t-complex testis expressed 1; T-complex testis-specific protein 1; T-complex testis-specific protein 1 homolog; TCTEX-1
基因别名: AGS2; Dynlt1; Tctel1; Tctex-1; Tctex1
UniProt ID: (Rat) Q9Z336, (Mouse) P51807
Entrez Gene ID: (Rat) 83462, (Mouse) 21648




